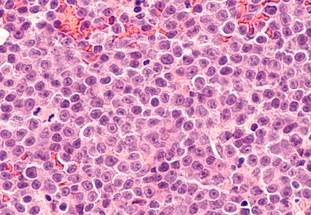
ReachMD Healthcare Image

Scientists Find Core Regulatory Circuit Controlling Identity of Aggressive Leukemia
A collaboration between scientists from St. Jude Children’s Research Hospital and Dana-Farber Cancer Institute uncovered four proteins that govern the identity of anaplastic large cell lymphoma (ALCL), an aggressive form of cancer. These proteins comprise a core regulatory circuit (CRC) that surprisingly incorporates a dysregulated signaling protein. Establishing the CRC for this lymphoma gives researchers insight into potential vulnerabilities that may be future therapeutic targets. The findings were published today in Cell Reports Medicine.
“Mutations in signaling pathways have long been known to drive oncogenic transformation and tumor progression,” said senior co-corresponding author Mark Zimmerman, PhD, currently of Foghorn Therapeutics, previously of Dana-Farber Cancer Institute and Boston Children’s Hospital. “Our new results show a mechanistic link in this aggressive T-cell lymphoma between aberrant signaling pathway activation and the dysregulated gene expression that is a hallmark of these tumor cells.”
ALCL patient tumors and models showed significant dysregulation of a protein called signal transducer and activator of transcription 3 (STAT3). STAT3 is a signaling protein that integrates information from other proteins, acting as a transcription factor (a protein involved in regulating the copying of genetic information from DNA into messenger RNA).
“We have found how dysregulation of the signaling protein STAT3 is central to enforcing ALCL cancer identity,” said co-corresponding author Brian J. Abraham, PhD, St. Jude Department of Computational Biology. “A healthy cell has a ‘Board of Directors’ made up of a few dominant regulators, and STAT3 gets ‘promoted’ from a division chief to a full board member with all the rights and powers that grants.”
Among the genes it controls, STAT3 increases expression of the protein MYC, which is well-known to be associated with cancers. Nearly every ALCL cell line tested showed either a mutation in STAT3 or in a protein that signals to STAT3, causing it always to be always “on” and directing gene expression, promoting perpetual cell growth through its targets.
The findings have implications for treatment because drugs that target the STAT family of proteins and other proteins that signal through STAT3 already exist.
Finding a core regulatory circuit for all ALCL subtypes
“Transcription factors and proteins that regulate the oncogenic gene expression programs are emerging as some of the most direct and effective targets for cancer therapy,” said first author Nicole Prutsch, PhD, Dana-Farber Cancer Institute and Boston Children’s Hospital. “STAT3 was already a recognized transcriptional activator in ALCL, but our research has identified a core transcriptional regulatory circuit hijacked by STAT3 to drive genes essential for ALCL cell growth.”
STAT3 hijacks three transcription factors that comprise the CRC: BATF3, IRF4 and IKZF1. All were expressed at high levels in ALCL cells, although they lacked any cancer-causing mutations. They were also identified as potential vulnerabilities in the DepMap Consortium gene knockout studies. When the scientists lowered the expression of any of these proteins, it significantly reduced cancer cell growth, demonstrating the centrality of the CRC.
“This is the first core regulatory circuit, to our knowledge, identified for ALCL,” Abraham said. Of the two major known molecular ALCL subtypes, anaplastic lymphoma kinase (ALK)-positive has an 80% survival rate, while ALK-negative has a 48% survival rate. Contrary to these differences, the researchers found both types relied on the same CRC.
“ALCL represents a diverse group of T-cell lymphomas with distinct clinical behaviors,” Prutsch said. “While ALK-positive cases respond well to ALK inhibitors, ALK-negative ALCL is highly aggressive and possesses limited targeted therapy options, highlighting the critical need for new treatment strategies.”
To understand the difference between the subtypes and find potential vulnerabilities, the researchers mapped special complexes of DNA and proteins called super-enhancers. These clusters of transcription-regulating elements are known to influence gene expression tightly. In cancers, super-enhancers can play a role in maintaining the cancer’s identity as a malignancy.
The scientists found that super-enhancers that differed among ALCLs converged to highlight the same CRC across ALCL tumors and models.
“The core regulatory circuit appears to be common across what have historically been treated as distinct diseases,” Abraham said. “Regardless of if an ALCL cell is ALK-positive or ALK-negative, it relies on the expression and the positive feedback provided by this circuit to stay ALCL.”
